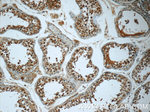
C2orf67 Antibody in Immunohistochemistry (Paraffin) (IHC (P))

Search
Proteintech
C2orf67 Polyclonal Antibody
{{$productOrderCtrl.translations['antibody.pdp.commerceCard.promotion.promotions']}}
{{$productOrderCtrl.translations['antibody.pdp.commerceCard.promotion.viewpromo']}}
{{$productOrderCtrl.translations['antibody.pdp.commerceCard.promotion.promocode']}}: {{promo.promoCode}} {{promo.promoTitle}} {{promo.promoDescription}}. {{$productOrderCtrl.translations['antibody.pdp.commerceCard.promotion.learnmore']}}
产品信息
24183-1-AP
种属反应
宿主/亚型
分类
类型
抗原
偶联物
形式
浓度
规格
纯化类型
保存液
内含物
保存条件
运输条件
产品详细信息
Immunogen sequence: MTPALREAT AKGISFSSLP STMESDKMLY MESPRTVDEK LKGDTFSQML GFPTPEPTLN TNFVNLKHFG SPQSSKHYQT VFLMRSNSTL NKHNENYKQK KLGEPSCNKL KNILYNGSNI QLSKICLSHS EEFIKKEPLS DTTSQCMKDV QIILDSNITK DTNVDKVQLQ NCKWYQENAL LDKVTDAEIK KGLLHCTQKK IVPGHSNVPV SSSAAEKEEE VHARLLHCVS KQKILLSQAR RTQKHLQMLL AKHVVKHYGQ QMKLSMKHQL PKMKTFHEPT TILGNSLPKC TEIKPEVNTL TAENKLWDDA KNGFARCTAA EIQRFAFSAT GLLSHVEE (1-337 aa encoded by BC126155)
靶标信息
C2orf67, also termed as chromosome 2 open reading frame 67, encodes a 705 amino-acid protein. It exists a variant, which encodes 987 amino-acid protein. The C2orf56 may express in lymphoid /immune and nervous system. The specific function of C2orf67 is still non-known.
仅用于科研。不用于诊断过程。未经明确授权不得转售。
篇参考文献 (0)
生物信息学
蛋白别名: KAT8 regulatory NSL complex subunit 1-like protein; KIAA1267-like; male-specific lethal 1 homolog; MSL1v2; unnamed protein product
基因别名: 1110028C15Rik; 1190030G24; AI427598; C2orf67; C430010P07Rik; KANSL1L; Kiaa4189; mKIAA4189; MSL1v2
UniProt ID: (Human) A0AUZ9, (Mouse) Q5DTI6
Entrez Gene ID: (Human) 151050, (Mouse) 68691